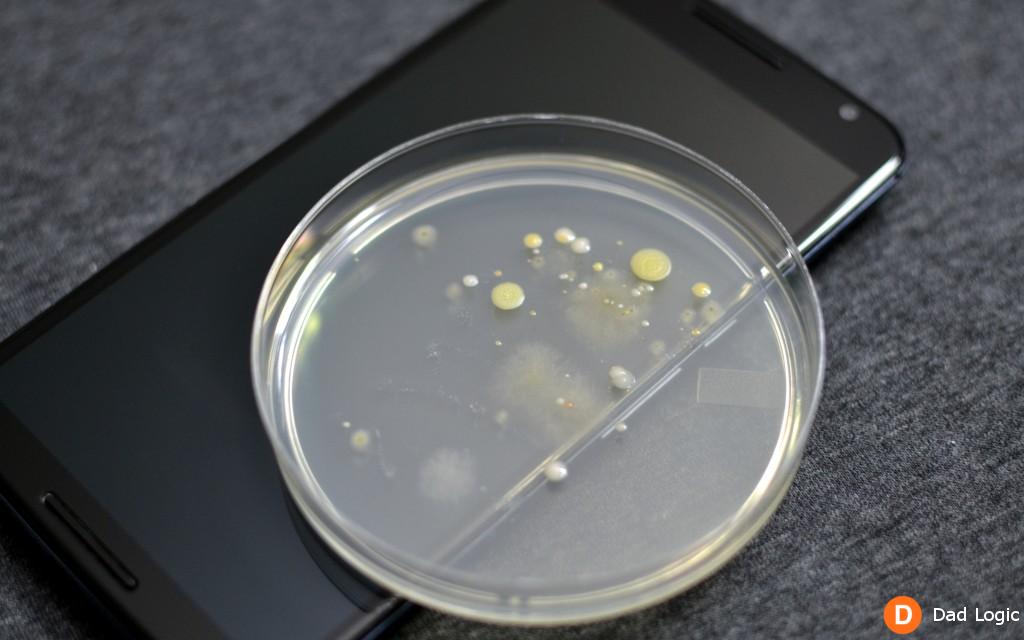
PhoneSoap-06
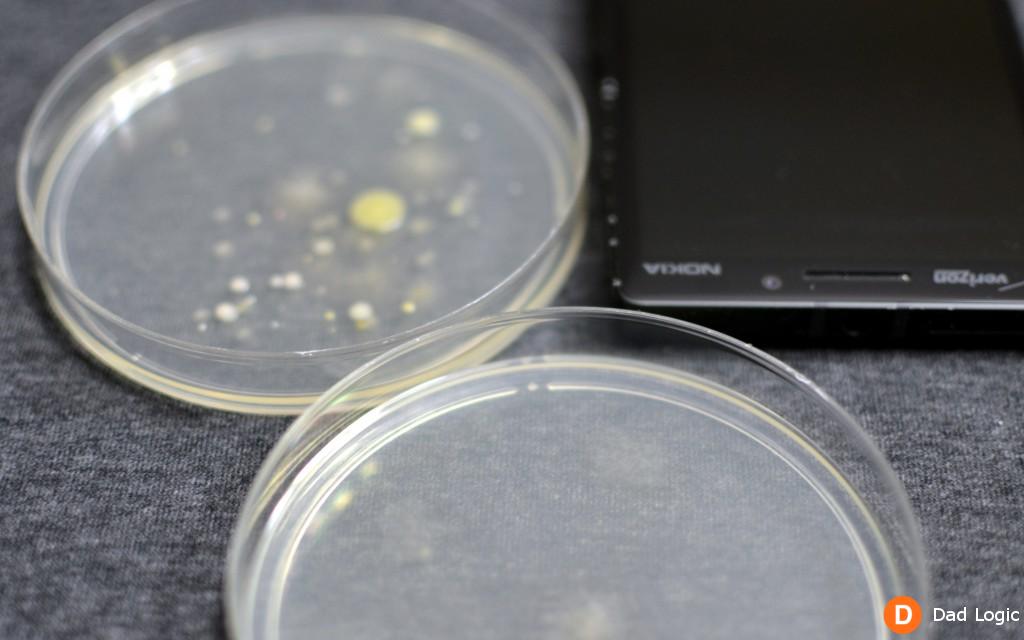
PhoneSoap-02

According to a study by Stanford University students, your phone is covered with 18 times more germs than a toilet handle. I don’t know if they tested phones owned by parents, but I would assume the germ count would be even higher. Children touch everything and rarely wash their hands. It makes me cringe to think of how many germs are being transferred to my phone when I let my son borrow it to watch Netflix.
I was approached to test a product called the PhoneSoap Charger which uses UV light to safely get rid of bacteria. I have to admit, I was skeptical. I had my mind made up that only chemicals or disinfecting wipes could get rid of germs. I doubted that a UV light in a box could do anything, but agreed to give it a try. And so, when the PhoneSoap Charger arrived on my doorstep, I didn’t just plug it in and accept that my phone was cleaned. I channeled all that I could remember from high school biology, ordered some petri dishes from Amazon, and put this thing to the test.
I ordered more petri dishes than I really needed, so I decided to test a few objects around the house to get a baseline. In the photo above, you can see a gross looking image of the bacteria that grew after I swabbed the bottom of my running shoes. I had just completed a 5K earlier in the day, which took me though dirt trails, grass, and other outdoor goodness. I may or may not have wiped my feet before coming in the house, but I don’t know if that would have made a difference. The results were pretty colorful.
With that baseline in place, I tested my son’s iPad. Considering how often my son takes his iPad with him to the bathroom, I was expecting this one to be worse than the shoe sample. Surprisingly, it didn’t have too much growth after giving it 72 hours to incubate.
The 6″ screen on my Nexus Six smartphone was too large to fit inside the PhoneSoap charger, but I tested it for germs anyway. I was glad to see that the bacteria growth was minimal since this is a phone I always carry with me.
And finally it was time to see what the PhoneSoap Charger could do. I swabbed my Nokia Lumia Icon (4″ screen) for a “before” sample, closed the lid, and a few minutes later the blue light turned off to say my phone had been sanitized.
In the photo above, you can see the before and after result. The top petri dish is the “before” and shows a few different types of bacteria (I let it incubate for 72 hours). The bottom dish shows how much of a difference one sanitation cycle can make. The dish has hardly any growth, which is impressive when you consider that the swabs were taken just five minutes apart.
Next, I tested my wife’s iPhone which has a thick case that is perfect for holding in germs. Even with the added bulk, I was able to close the lid on the PhoneSoap Charger without a problem. A neat feature is that you can swap out the charging plug inside the PhoneSoap to whatever your phone needs. This makes it compatible with iPhones, Androids, or whatever you might have.
I found that it was convenient to just leave the charger on my nightstand so that I could clean the phone and charge it overnight. The UV light turns off after the cleaning cycle and then the phone continues charging as long as needed. I could still hear my phone’s notifications when it was in the charger, so I never missed my alarm clock.
The iPhone results were terrifying and interesting. The top petri dish shows the ridiculous amount of bacteria that grew after I swabbed the phone and case. The bottom dish shows the minimal bacteria that was present after just one cleaning cycle in the PhoneSoap Charger. I think that the case contributed to the germ count because of all the nooks and crannies it has on the back. I have to say, this was a pretty dramatic result. I am still shocked that my son’s iPad wasn’t the dirtiest of the bunch.
After seeing the results, I am looking forward to having the PhoneSoap Charger around when cold and flu season arrives. My son likes to use the back of his hand to wipe his runny nose and he likes to use my phone to play games, which is a pretty gross combo when I think about it. I think PhoneSoap will be put to good use in this household.
The PhoneSoap Charger retails for $59.95 and can be found at www.phonesoap.com. Although I was skeptical, the results from my unscientific testing made me a believer in the PhoneSoap Charger. It is amazing that 5 minutes of UV light can make that much of a difference.